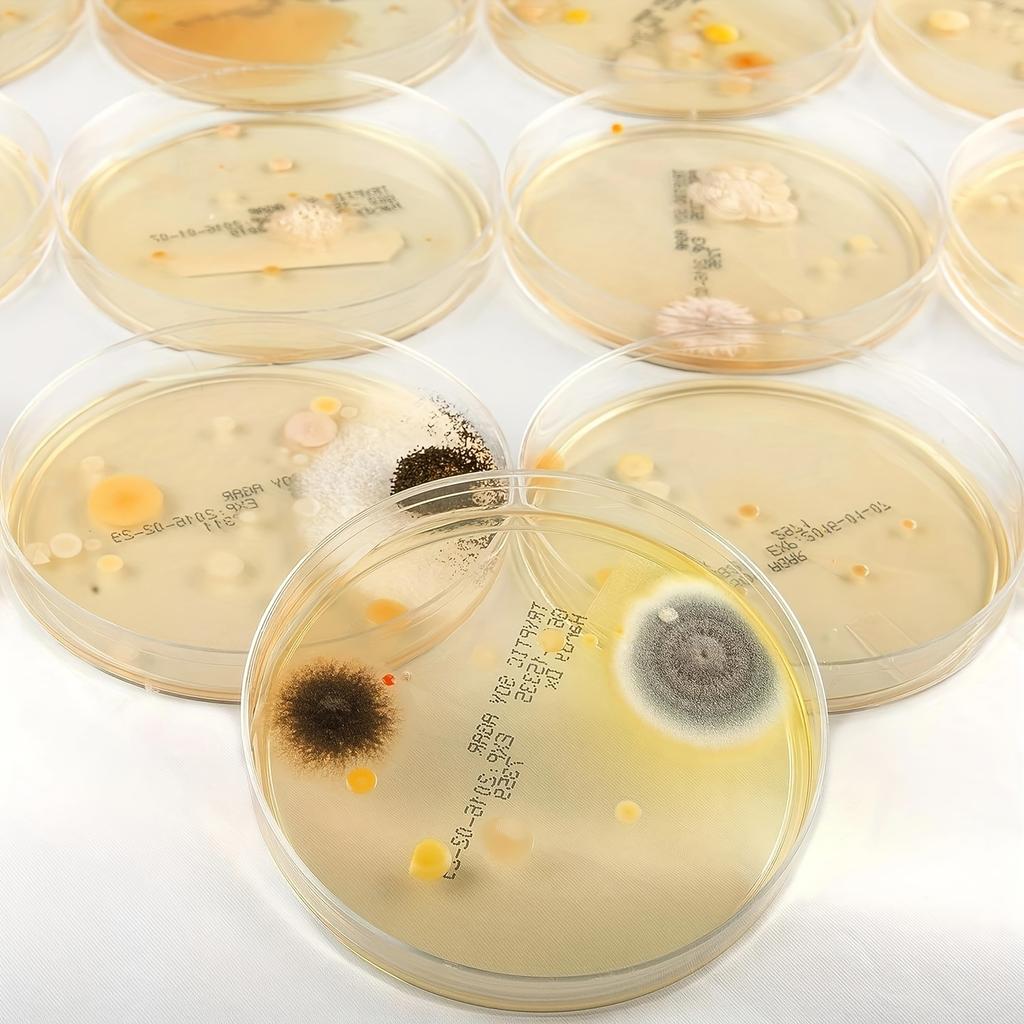
Fantastic Bacteria Science Kit - Petri Dish Science Kit - Top Science Fair Project Kit
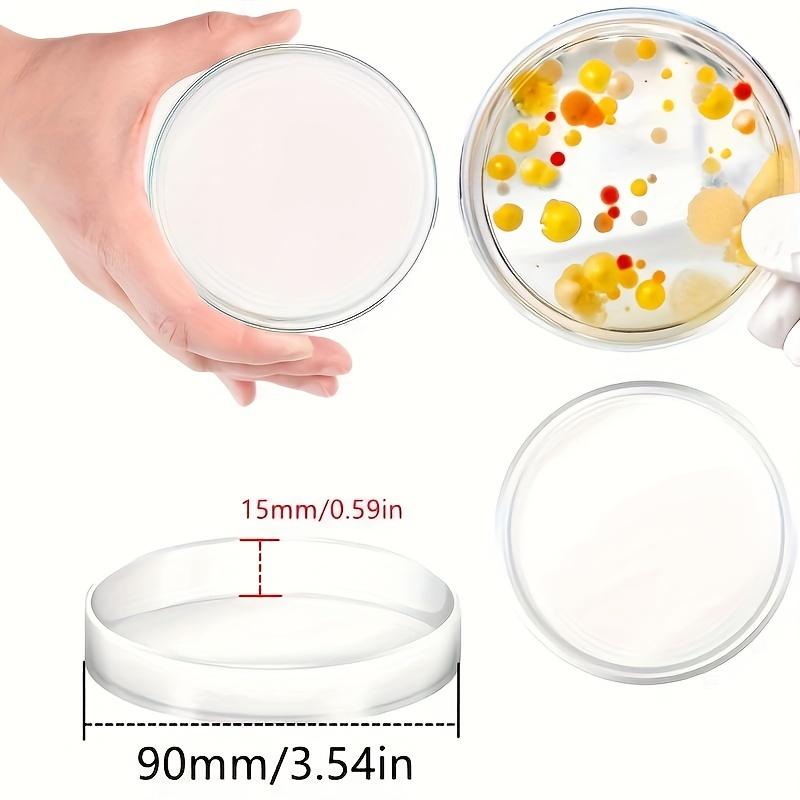
Fantastic Bacteria Science Kit - Petri Dish Science Kit - Top Science Fair Project Kit
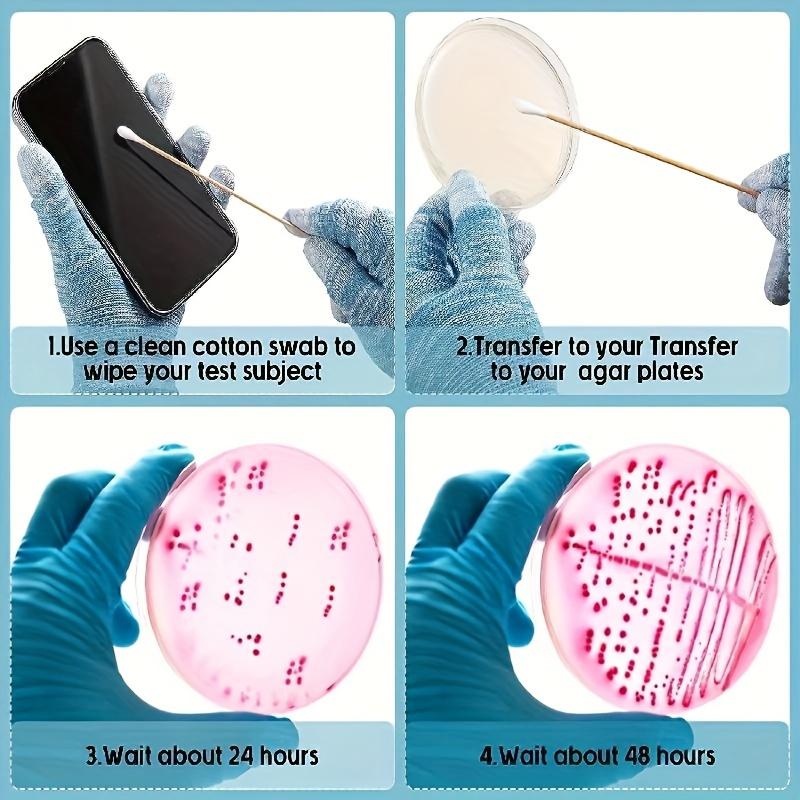
Fantastic Bacteria Science Kit - Petri Dish Science Kit - Top Science Fair Project Kit

The website doesn't support your browser. Please update your browser or download a different one
Fantastic Bacteria Science Kit - Petri Dish Science Kit - Top Science Fair Project Kit
Current price
Price €15VAT included
Colour and size
1 SetDelivering across 🇦🇹 Austria
Delivery 9‑12 business days
Your payments and privacy are safe









Similar products